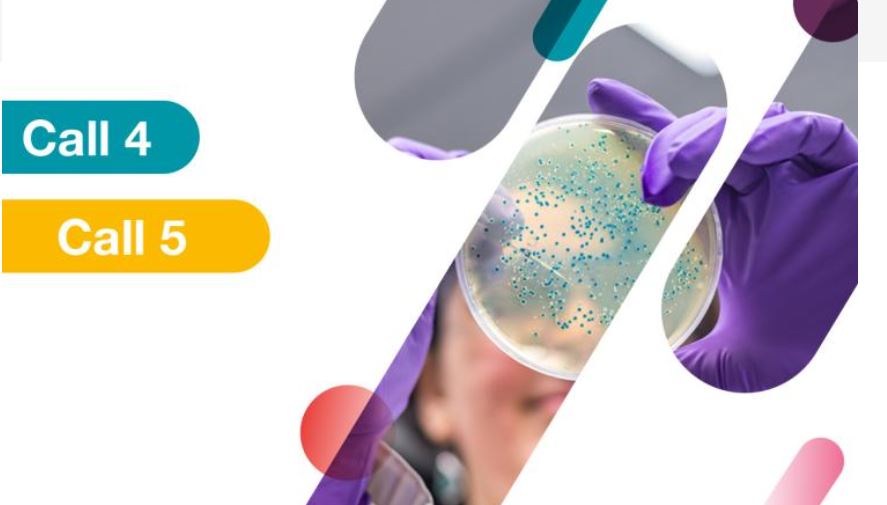
IHI call 4 call 5 topics

Horizon Europe Információs Pont
2023. június 7-én került megrendezésre a LIFE Információs Nap. Az Európai Bizottság CINEA ügynöksége 2023. április 18-án, illetve május 11-én tette közzé a 2023. évi LIFE pályázati felhívásokat és a hagyományos projektek esetén a pályázatbenyújtási határidők szeptember elejével kezdődnek. Az Európai Bizottság 2023-ban mintegy 611 millió euró pályázati összeget különített el a LIFE négy alprogramja keretében pályázó szervezek számára.
Az információs napon elhangzott előadások összefoglaló jellegűek, melyeket az egyes témákra kattintva lehet elérni, de feltöltésre került a holnapra is.
1. A LIFE program általános bemutatása, támogatott projekttípusok ismertetése
2. A 2023. évi LIFE pályázati felhívás: prioritások és újdonságok: Természet és biodiverzitás alprogram
3. A 2023. évi LIFE pályázati felhívás: prioritások és újdonságok: Körforgásos gazdaság és életminőség alprogram
4. A 2023. évi LIFE pályázati felhívás: prioritások és újdonságok: Éghajlatváltozás mérséklése és alkalmazkodási alprogram
5. A 2023. évi LIFE pályázati felhívás: prioritások és újdonságok: Tiszta energiára való átállás alprogram
Az egyes projektek megvalósítása önerő igényes, de annak finanszírozását a "Közvetlen uniós pályázati programok hazai koordinációja, önerő-támogatás" című pályázat segíti, melynek az információs napon elhangzott ismertetője ITT található.
Előkészítés alatt állnak az Innovative Health Initiative pályázati felhívásai, mely számos, az egészségügy területét és annak a körforgásos gazdaságba való bekapcsolódását segíti, illetve innovatív logisztikai megoldások tervezésére, fejlesztésére is kínál pályázati lehetőséget ezen a szakterületen a jövőben. A 2023. nyarán megjelenő IHI pályázati felhívások várható témáiról, valamint a kapcsolódó információs napokról készített összefoglaló ITT érhető el.
Innovation Fund Small Scale Projects kategóriában jelent meg az alacsony szén-dioxid kibocsátású technológiák és folyamatok innovációját támogató tevékenységeket elősegítő felhívás (beleértve a környezetbarát szén-dioxid-leválasztását és felhasználását), mely már a projektek előkészítésére is támogatást kíván nyújtani. A pályázat összefoglalója ITT érhető el.
Az Európai Bizottság csaknem 60%-kal növeli a LIFE program finanszírozását a következő időszakra. A LIFE négy új alprogramra is kiterjed:
- természet és biológiai sokféleség
- körforgásos gazdaság és életminőség
- éghajlatváltozás mérséklése és az ahhoz való alkalmazkodás
- tiszta energiára való áttérés.
Az alprogramok leírása ide kattintva érhető el.
Az egyes pályázattípusok közzététele a napokban várható, de a benyújtási határidők várhatóan 2023. szeptemberében lesznek. A projektek megvalósításához önerő bevonása szükséges, melyre megoldást kínálhat az előző hírünkben bemutatott pályázati lehetőség, melyet ITT talál.